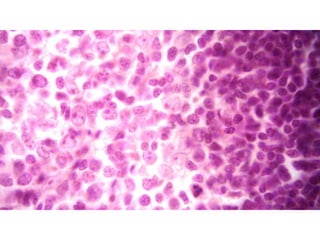

Embed presentation
Download to read offline















This document discusses the histological features of a spleen section stained with hematoxylin and eosin. It notes the absence of a marginal zone surrounding the T-cell area and presence of an erythrocyte-rich perifollicular zone around both the T- and B-cell compartments. It also comments that the structure of the red pulp and perifollicular zone are difficult to discern in a standard H&E stained section.